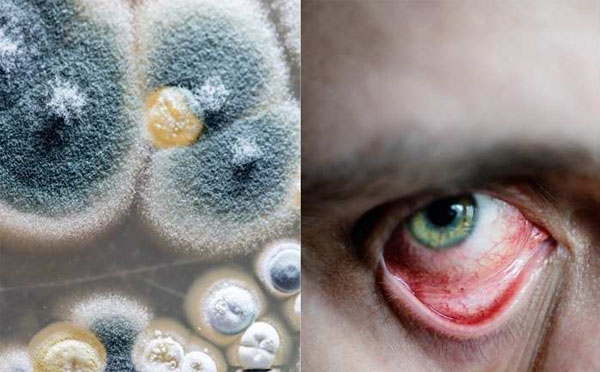

ന്യൂഡല്ഹി : കോവിഡിനൊപ്പം ബ്ലാക്ക് ഫംഗസും പിടിമുറുക്കിയതോടെ പ്രതിരോധമരുന്നിനായുള്ള നടപടി കേന്ദ്രസര്ക്കാര് ഊര്ജ്ജിതമാക്കുകയായിരുന്നു. ഇതോടെ യുഎസില് നിന്നും ബ്ലാക്ക് ഫംഗസ് ചികിത്സയ്ക്കായുള്ള മരുന്ന് എത്തിച്ചു. ഇതിന്റെ ഭാഗമായി ആംബിസോം എന്ന ഇന്ജക്ഷന്റെ രണ്ട് ലക്ഷം ഡോസാണ് കഴിഞ്ഞ ദിവസം യുഎസില് നിന്നും ഇന്ത്യയിലേക്ക് എത്തിയത്. ബ്ലാക്ക് ഫംഗസ് ചികിത്സയ്ക്ക് ഇന്ത്യയ്ക്ക് ആവശ്യമുള്ള മരുന്നുകള്് ലോകത്തില് എവിടെ നിന്നെങ്കിലും സംഘടിപ്പിക്കണമെന്ന് വിവിധ മന്ത്രാലയങ്ങള്ക്ക് പ്രധാനമന്ത്രി നരേന്ദ്ര മോദി കഴിഞ്ഞദിവസം നിര്ദ്ദേശം നല്കിയിരുന്നു. ബ്ലാക്ക് ഫംഗസ് രോഗബാധയുടെ ചികിത്സയ്ക്ക് ഉപയോഗിക്കുന്ന ഒരു മില്ല്യണ് ആംഫോടെറിസിന് മരുന്നുകള് അമേരിക്കയില് നിന്നും നേരത്തെ ഇന്ത്യയില് എത്തിയിരുന്നു.
2021-05-30